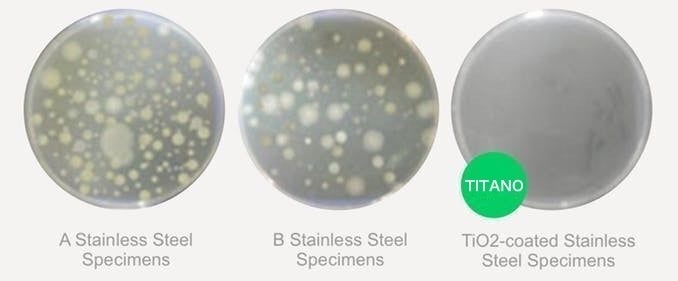

チタンケトル「FLOW(フロー)」とは

チタン製ケトル「FLOW(フロー)」は、チタン製品の専門ブランドである「TITANO(チタノ)」が開発したハイエンドケトルです。医療現場で使用されるグレードの純チタンをすべてのパーツに使用し、機能性とデザイン性を兼ね備えたアイテムです。
スタイリッシュかつ、シンプルなデザインはそのままインテリアとして置いておいても邪魔になりません。どんなスタイルの部屋にもマッチするので、片付けするのを忘れてしまうほど。
異なる素材を組み合わせた機能的なデザイン
チタンケトル「FLOW」は、金属素材と木材という全く異なる素材を組み合わせることで、外観の美しさと機能性を両立しました。

ハンドル部分にはブナ材を使用し、無機質になりがちな金属素材に木材の温かさをプラス。ケトルの熱を伝えないのはもちろん、自然と手に馴染むデザインです。

ケトルの表面はチタンでしか表現できない独特なチタングレー。適度な研磨処理を施すことで光の反射を防ぎ、マットな手触りで高級感のある仕上がりに。余分なコーティングや装飾を省き、チタンならではの自然な色合いにこだわりました。

フタには簡易的なロック機構が設けられており、本体にセットしてツマミを回すことで、本体を傾けたときにフタが落ちてしまうのを防いでくれます。
湯量の調節がしやすい全体設計
もちろん外観だけでなく、使いやすさにもこだわりました。
「FLOW(フロー)」のハンドル部分は、やや長めに設計。コーヒードリップに最適な重量バランスを実現しました。

また「湯量調節のしやすさ」にも工夫を凝らしました。注ぎ口の先端に向けて開いた形状にすることで、湯量のコントロール性を高めています。

チタンが選ばれる理由
純チタンが持つ、天然の抗菌性と素材を生かす力
「FLOW」には、医療グレードの純チタンを使用しています。チタンは非常に錆びにくく、耐久性に優れる素材であり、細菌の繁殖を防ぐ天然の抗菌性があることが知られています。
チタンは空気に触れると、チタン原子の非常に薄い層が酸素と相互作用して、チタニアと呼ばれる二酸化チタン(TiO2 )の作用でナノコーティングを生成します。チタニアには、細菌の繁殖を防ぐ天然の抗菌性があります。
下記の写真は、ペトリ皿に一般的なステンレス鋼標本2種類(AとB)とチタニア(TiO2)をコーティングしたステンレス鋼標本を置いて24時間経過した時点での細菌と大腸菌コロニーの繁殖状態を示しています。
細菌:
大腸菌コロニー:

画像を見てわかるように、右端のチタニアでコーティングされた標本は細菌の繁殖がほぼありません。これが、チタンが素材として選ばれている理由の1つです。
また、チタン素材は、食べ物・飲み物の風味を変えない素材としても注目を集めています。
チタンだから実現できた「軽量性」と「丈夫さ」

「FLOW」の本体重量はたったの218グラム。手に取った瞬間、その軽さに驚くはず。チタンの重量は、鉄と比べて約6割ほどしかありません。そのうえ、金属としての強度は鉄の約2倍、アルミの約3倍と言われており、非常に丈夫な金属なのです。
そのため、「FLOW」はアウトドア環境に持ち出すケトルとしても最適です。バックパックやトートバッグに入れて、キャンプやピクニックでもコーヒータイムを楽しめます。

オプションのストレーナーで使い方の幅が広がる
「FLOW」にはオプションでチタン製ストレーナーが選べます。コーヒー用のドリップケトルが、ストレーナーとセットでお使いいただくことで、ティーウェアとしてもお使いいただけます。

使い方はストレーナーに茶葉を入れて、ケトル本体にセットするだけ。チタン製なので、ケトルの金属臭がお茶に移ってしまうこともなく、茶葉本来の味を楽しめます。

チタン素材から生まれた究極のケトル
デザイン性、耐久性、機能性を兼ね備えた「FLOW」は、私たちの暮らしに自然とフィットする究極のケトルです。普段使いのコーヒーケトルとして、またアウトドアに持ち出す丈夫なケトルとして、様々なシーンで活躍するプロダクトであると確信しています。

製品名:FLOW
サイズ:高さ18cm、直径 8.5cm(上部)、直径 11.3cm(下部)
重量:218g
容量:900ml
材質:純チタン(本体、フタ)、ブナ材(ハンドル)
※直火での加熱はもちろん、IHにも対応しています。直火の際は、ハンドル部分は木材なので焦がさないようにご注意ください。

TITANO™️ について
環境に配慮すること、安全を考えること、そして料理や飲料の味そのものを味わう楽しみを発見する楽しみを感じられること。いつも使っている製品の素材に目を向けてみることで、今までわからなかったことに気づくことがあります。私たちTITANO(チタノ)がたどり着いたのがチタンという金属素材です。
金属素材のチタンは、軽さ、強さ、錆びにくさ、といった特性から航空宇宙分野などで使われる特殊な金属として知られています。しかし、無味無臭で天然の抗菌性があり、体に優しくアレルギーを起こしにくいなど、日常生活においても有益な点が多い金属であることはまだまだ一般的には知られていません。
そんなチタンの素材としての特性を活かし、チタンをより身近に感じられるプロダクトをお届けするのがチタン専門ブランド「TITANO」のコンセプトです。

■特定商取引法に関する記載
◯ 販売事業者名: 株式会社メディアジーン
◯ 事業者の所在地:〒150-0044 東京都渋谷区円山町23−2 アレトゥーサ渋谷 6F
◯ 事業者の連絡先:Tel: 03-5784-6702 メール: contact@titano.jp
※こちらでは当該製品に対するお申し込み、質問等は受け付けておりません。
◯ リターン価格:各リターン記載の通り
※ 商品内容に関してはリターン欄記載の通り
※ リターン価格とは別にcampfire(machi-ya)のシステム利用料として1支援毎に200円(税別)が支援者様の負担となります。尚、このシステム利用料はcampfireが受け取るもので、当社が受領するものではございません。
◯ 申込期限:当ページ記載のプロジェクト終了期限通り
◯ 支払い方法:クレジットカード払い(Visa/Mastercard/JCB/Diners Club/American Express)/コンビニ払い(全国の主要コンビニエンスストア)/銀行振込(銀行ATM・ネットバンキング)/auかんたん決済/ソフトバンクまとめて支払い・ワイモバイルまとめて支払い/ドコモ払い
◯ 支払い時期 :当プロジェクトは「All-in型」の為、目標達成の如何に問わず、ご契約が成立しリターンをお届けします。その為、お申込みと同時にご利用の決済方法に準じてご請求となります。
◯ 引渡し時期: 各リターン詳細に記載の発送予定月を引き渡し時期とします。但し、開発・生産状況によって遅れが生じる場合がありますのでその際は当プロジェクトページ内の「活動報告」または購入者へのメール等で連絡します。
◯ キャンセル・返品: 当プロジェクトは「All-in型」の為、お申込み完了をもって契約が成立いたします。その為、お客様都合による返品・キャンセルはできませんのでご注意ください。尚、製品到着後に破損や初期不良がある場合には交換させていただきますので「メッセージで意見や問い合わせを送る」から、または納品書記載の連絡先までお問い合わせください。
※上記以外の事項に関しては、お取引の際に請求があれば遅延なく提示いたします。
最新の活動報告
もっと見るFLOWリターン配送のご案内
2021/12/22 17:03ご支援者の皆さまこの度は、TITANO FLOW Kettleをご支援いただき誠にありがとうございました。また、度重なる配送の遅延、申し訳ございません。ようやく全ての製品が配送拠点に到着し、現在は発送作業を行なっております。12/23(木)より順次発送を開始いたしますので、あと数日で皆さまのお手元にお届けできるかと存じます。また、全てのリターンの発送完了ができましたら再度ご報告いたします。お待たせし誠に申し訳ございませんが、もう少々お待ちくださいますようお願いいたします。TITANO もっと見るFLOWリターン遅延のお詫び
2021/12/20 16:41ご支援をいただきました皆さまご案内が大変遅くなりまた遅延が発生しておりまして誠に申し訳ございません。リターン配送の進捗ですが、前回活動報告にてご案内した製品は国内配送拠点に届いておりますが、製品の一部不足が発覚しまして、不足分の配送を待っている状況です。不足分の手配などの対応に追われてしまい、皆さまへのご連絡が大変遅くなりまして申し訳ございません。ただこちらも国内には到着しており通関作業が完了いたしました。現在は、配送業者様への登録や関税支払いの手続きを進めている状況で、こちらの作業に時間を要しております。一度全ての製品を受領するため、大変ご迷惑をおかけしております。年内には皆さまの元に発送できるよう早急に手続きを進めている状況です。度重なる遅延誠に申し訳ございません。TITANO もっと見るFLOWリターン配送状況のご報告
2021/11/24 17:02FLOWをご支援いただきました皆さまご案内が大変遅くなりまして、申し訳ございません。また、お届けが大変遅くなっており誠に申し訳ございません。現在の状況についてですが、製品は工場を出荷し、無事、国内の港に届きまして、食品衛生法の届出など、通関作業を行なっております。この後ですが、通関を通過した後、国内の配送拠点へ配送、その後皆さまのお手元に届く流れとなります。通関には数日を要します。また国内配送拠点に届いた時点で再度ご案内いたします。この度は大幅な遅延発生しており大変申し訳ございません。重ねてお詫び申し上げます。お楽しみにしていただいているなか、大変恐縮ですが、今しばらくお待ちいただけますと幸いです。TITANO もっと見る





コーヒーの抽出を考えていたので,ストレーナーの変更は大変残念でした.
キャンペーン終了後、活動報告が全くありませんが、記載通り10月発送予定で進んでいますか?
アフターサポート(修理・パーツ販売など)はあるご予定でしょうか?取っ手の破損や本体の変形などを想定しています。ご回答頂けると幸いです。よろしくお願いいたします。